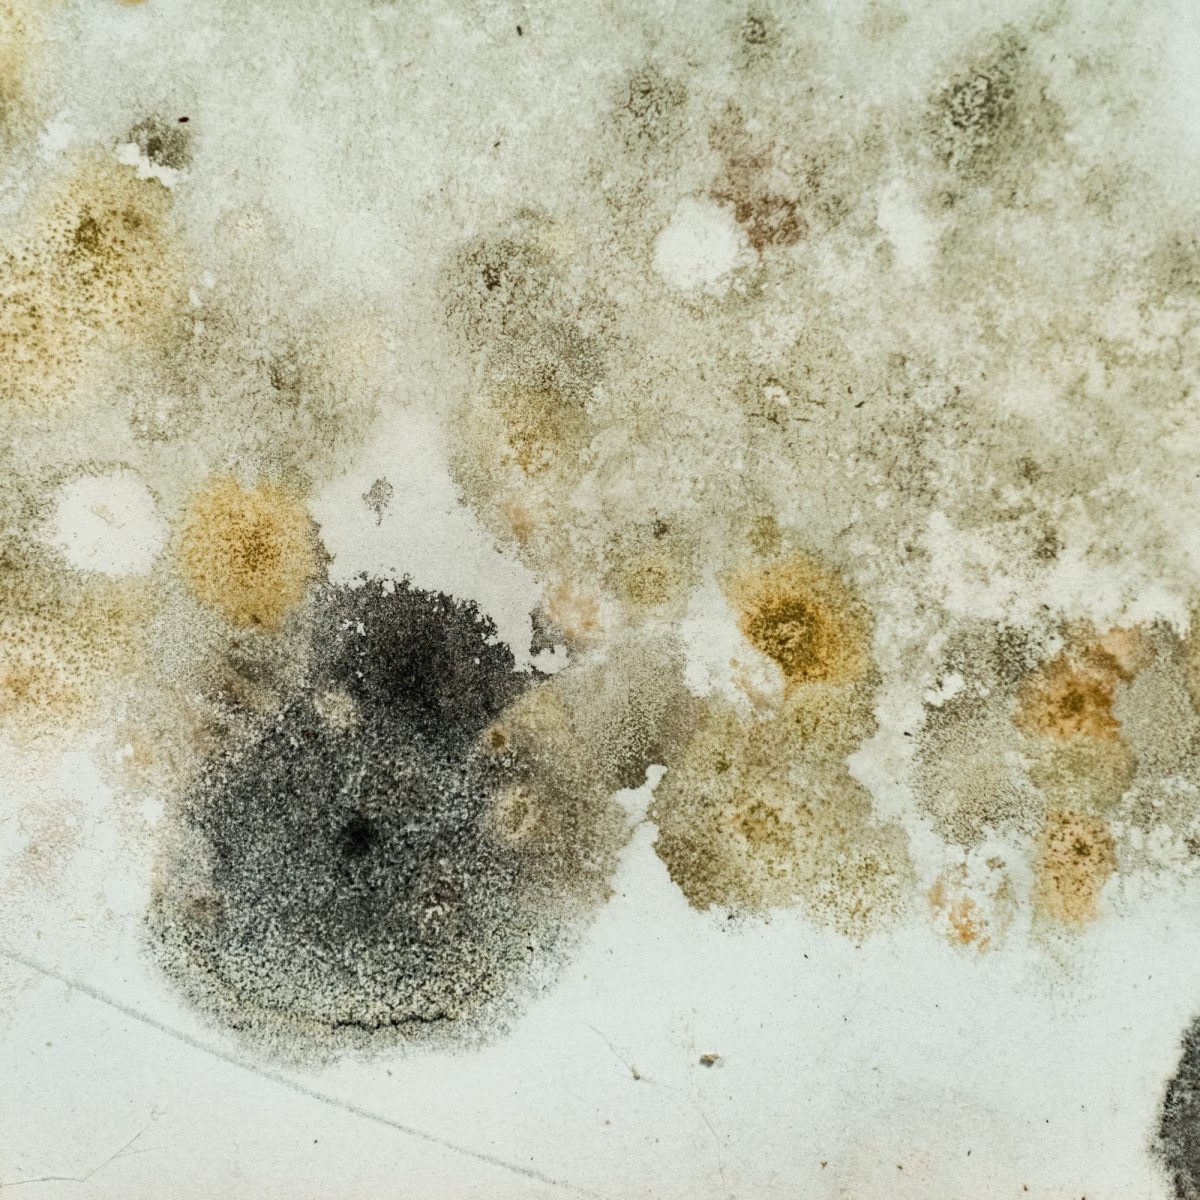
Smartwall mold 1

Basement Waterproofing

A Dry, Healthy Basement Starts Here
After heavy rain or melting snow, are you seeing water along your basement walls or floor, or noticing a damp, musty smell in your home? These are common signs of a basement water problem that shouldn’t be ignored.
At Ayers Basement Systems, we help homeowners across Michigan and Northern Indiana solve basement water issues for good. With over 40 years of experience, our trusted experts know how to pinpoint the source of the problem and design a permanent and dry solution for your home.
Free EstimateBasement Water Problems?
Your home is one of your family’s most important assets. When basement water threatens that investment, a professionally designed waterproofing system delivers reliable protection by resolving existing problems, preventing future damage, and keeping your home dry, safe, and structurally sound.
Water in your basement can lead to mold, structural damage, and unhealthy indoor air. Addressing the problem early with the right permanent waterproofing system helps keep your basement dry year-round.
-
Water in basement after heavy rain
 Sump Pumps
Sump PumpsWater in basement after heavy rain
-
Walls have mold or white chalky residue
 Wall Coverings & Flooring
Wall Coverings & FlooringWalls have mold or white chalky residue
-
Basement smells wet and musty
 Dehumidifier
DehumidifierBasement smells wet and musty
-
Water leaks down basement walls
 Drainage Systems
Drainage SystemsWater leaks down basement walls
-
Basement windows are letting water in
 Basement Windows
Basement WindowsBasement windows are letting water in
From beginning to end, their professionalism, communication, and efficiency were top notch. They did a FANTASTIC job and I feel so relieved that I won't have any more water in the basement. Recommend 100%.
-
Water in basement after heavy rain
 Sump Pumps
Sump PumpsWater in basement after heavy rain
-
Walls have mold or white chalky residue
 Wall Coverings & Flooring
Wall Coverings & FlooringWalls have mold or white chalky residue
-
Basement smells wet and musty
Dehumidifier
DehumidifierBasement smells wet and musty
-
Water leaks down basement walls
 Drainage Systems
Drainage SystemsWater leaks down basement walls
-
Basement windows are letting water in
 Basement Windows
Basement WindowsBasement windows are letting water in
Waterproofing Solutions
As your local basement waterproofing experts, we're here to provide you with the right solutions for your problems. Whether you have wet walls, leaky cracks, water coming in through the basement floor, or excessive humidity, we have the solution for you:
-
Drainage Systems
Drainage Systems
Our interior drainage solutions redirect water to keep your home dry.
-
Sump Pumps
Sump Pumps
A sump pump is essential for quickly removing water in your basement.
-
Wall Coverings & Flooring
Wall Coverings & Flooring
Transform your space into something brighter and more beautiful.
-
Basement Dehumidifier
Basement Dehumidifier
Powerful, energy-efficient dehumidifiers prevent dampness and mold.
-
Basement Windows
Basement Windows
Properly installed windows help protect against leaks.
Getting started is easy:
-
1
Request a FREE Estimate
Start by completing our short 1-minute questionnaire below.
-
2
Schedule Your Appointment
We’ll contact you to schedule a free estimate and inspection with one of our specialists.
-
3
Receive a Permanent Solution
We’ll examine the problem areas and present customized solutions based on our findings.
Get a free estimate
Complete our 3-question form, and we’ll be in touch shortly. Need help now? Reach us immediately at 1-866-379-1669.
Request a FREE estimate and get a same-day response.
Our Work
Before & Afters
-
After
 Before
Before Before
Before After
After
Basement Waterproofing and TripleSafe Sump Pump Installation in Hickory Corners, MI
-
After
 Before
Before Before
Before After
After
Sump Pump System Upgrade in Plymouth, MI
-
After
 Before
Before Before
Before After
After
Waterproofing a Basement to Enhance Home Sale Value in Morley, MI
-
After
 Before
Before Before
Before After
After
Basement Waterproofing in Hart, MI
-
After
 Before
Before Before
Before After
After
Expert Basement Waterproofing in East Lansing, MI
-
After
 Before
Before Before
Before After
After
Home Receives Basement Waterproofing System in Kalamazoo, MI
-
After
 Before
Before Before
Before After
After
Water Intrusion in Basement Causes Concern for Home's Stability in South Bend, IN
-
After
 Before
Before Before
Before After
After
Seeping Water in Cinder Block Walls, Turns to a Permanently Dry Space in Ludington, MI

What causes a wet basement?
The Clay Bowl Effect
Excavated soil that's replaced around a completed foundation isn't as dense and tightly packed as undisturbed soil farther away. As a result, water collects in the soil immediately surrounding the house, putting pressure on foundation walls and causing cracks.
Hydrostatic Pressure
The weight of the water in the soil around the foundation exerts pressure, forcing the water through cracks, gaps, holes, and around windows leading into the basement.
Testimonials
Trusted by Homeowners Like You
-
Adam was great to work with. He knows his products and their best uses. Adam helped me make informed decisions on what needed to be done to my old Michigan basement to protect my house. The project was presented to me as urgently needed and other things that could be addressed at a future time.
-
Was courteous and worked very hard. Was willing to let me work in a bedroom while they were underneath and offered a lending hand. Workmanship was top notch. Took time explaining everything at start of day and at the end.
-
These guys were polite, professional and a pleasure to have around. They asked often if I had any questions, and explained every step of the process.
-
These guys were awesome!! Very professional and friendly.
-
I choose Ayers basement based on name and excellent reputation. Zach, Gabe and Cliff very professional and take pride in what they do.
Common Questions
Frequently Asked Questions
-
Many Michigan homes were built with basement walls made from porous materials like concrete block or poured concrete. While strong, these materials are not naturally waterproof. Over time, soil around your foundation becomes saturated, and water can seep through tiny pores, cracks, or joints in the walls and floor.
Without a proper drainage system to collect and remove this water, moisture can build up, leading to dampness, leaks, and ongoing basement issues. This is why water often appears after heavy rain or snowmelt.
Installing a basement waterproofing system that includes an effective drainage solution and wall protection can safely manage water and keep your basement dry long term.
-
Heavy rainfall, snowmelt, and high humidity levels allow moisture to build up around your foundation. That moisture can seep through porous concrete walls and floors or enter through small cracks, creating damp conditions where mold and mildew can grow.
Even when mold is not visible, it can still be present behind walls, under flooring, or in other hidden areas, producing that familiar musty odor. Without proper drainage, waterproofing, and humidity control, the smell will continue to return.
At Ayers Basement Systems, we focus on stopping moisture at the source. By installing proven waterproofing and drainage systems designed for Michigan and Indiana homes, we help eliminate the conditions that cause musty odors and keep basements dry and healthy long term.
-
If you are dealing with water in your basement, a sump pump is often an important part of the solution. A sump pump is designed to collect and remove unwanted water before it can build up and cause flooding, standing water, or damage to your home.
At Ayers Basement Systems, we install our TripleSafe™ sump pump system for dependable, long-term protection. This system includes three pumps working together inside one liner. The primary pump handles everyday water removal. If water levels rise or the first pump cannot keep up, a second pump automatically turns on. The third pump is battery-powered, providing protection even during power outages when you need it most.
-
An interior waterproofing system is the most effective and reliable solution. Interior drainage systems are designed to manage water that seeps through foundation walls or up through the floor, safely collecting it and directing it to a sump pump for removal. These systems work with natural water pressure rather than fighting it, making them a long-term solution for basement water problems.
Exterior waterproofing may be recommended in certain situations, such as new construction or when foundation walls are fully exposed. However, exterior systems are typically more disruptive, more expensive, and not always necessary to solve the problem.
At Ayers Basement Systems, we evaluate your home to determine the best approach for your specific situation. Our goal is to design the right waterproofing solution to keep your basement dry for good.
-
Yes. Basement waterproofing installed by Ayers Basement Systems is backed by a lifetime warranty, giving you long-term peace of mind. Our warranty is fully transferable, so it stays with the home if you decide to sell. That added protection can be a valuable benefit for future homeowners as well.
We stand behind our systems because they are built to perform and installed by highly trained professionals. If you ever have a question or concern, our team is here to support you. Our goal is not just to fix your basement today, but to protect your home for the life of the system.
When you choose Ayers, you can feel confident knowing your investment is protected.
-
If your basement floods, act quickly to reduce damage and keep your home safe. If there is standing water near outlets or appliances, turn off power to the basement before entering. Remove the water as soon as possible using a sump pump, wet vacuum, or a water removal service. Then dry the area thoroughly with fans and dehumidifiers to help prevent mold and further damage.
It's important to address the cause of the flooding. Solutions like interior drainage systems, reliable sump pumps, and properly sealed basement windows can help redirect water and keep your basement dry. Our team can inspect your home and recommend a permanent waterproofing solution designed to stop basement flooding for good.
-
Why Is My Basement Getting Water After Snow Melt and Heavy Rain?

Why Is My Basement Getting Water After Snow Melt and Heavy Rain?
Basement flooding after snow melt? Learn why it happens and how to permanently fix it.
-
Does Exterior Foundation Waterproofing Work? Why It Won’t Keep Your Home Permanently Dry

Does Exterior Foundation Waterproofing Work? Why It Won’t Keep Your Home Permanently Dry
Even with gutters, grading, or window wells installed, moisture can enter your foundation as exterior fixes often hide growing problems.
-
Wet Basement After Rain? The Real Reasons Your Water Problems Don’t Disappear

Wet Basement After Rain? The Real Reasons Your Water Problems Don’t Disappear
Even when the rain stops, lingering soil saturation and hidden drainage issues can leave your basement vulnerable, learn why dry spells don’t always mean dry ba…